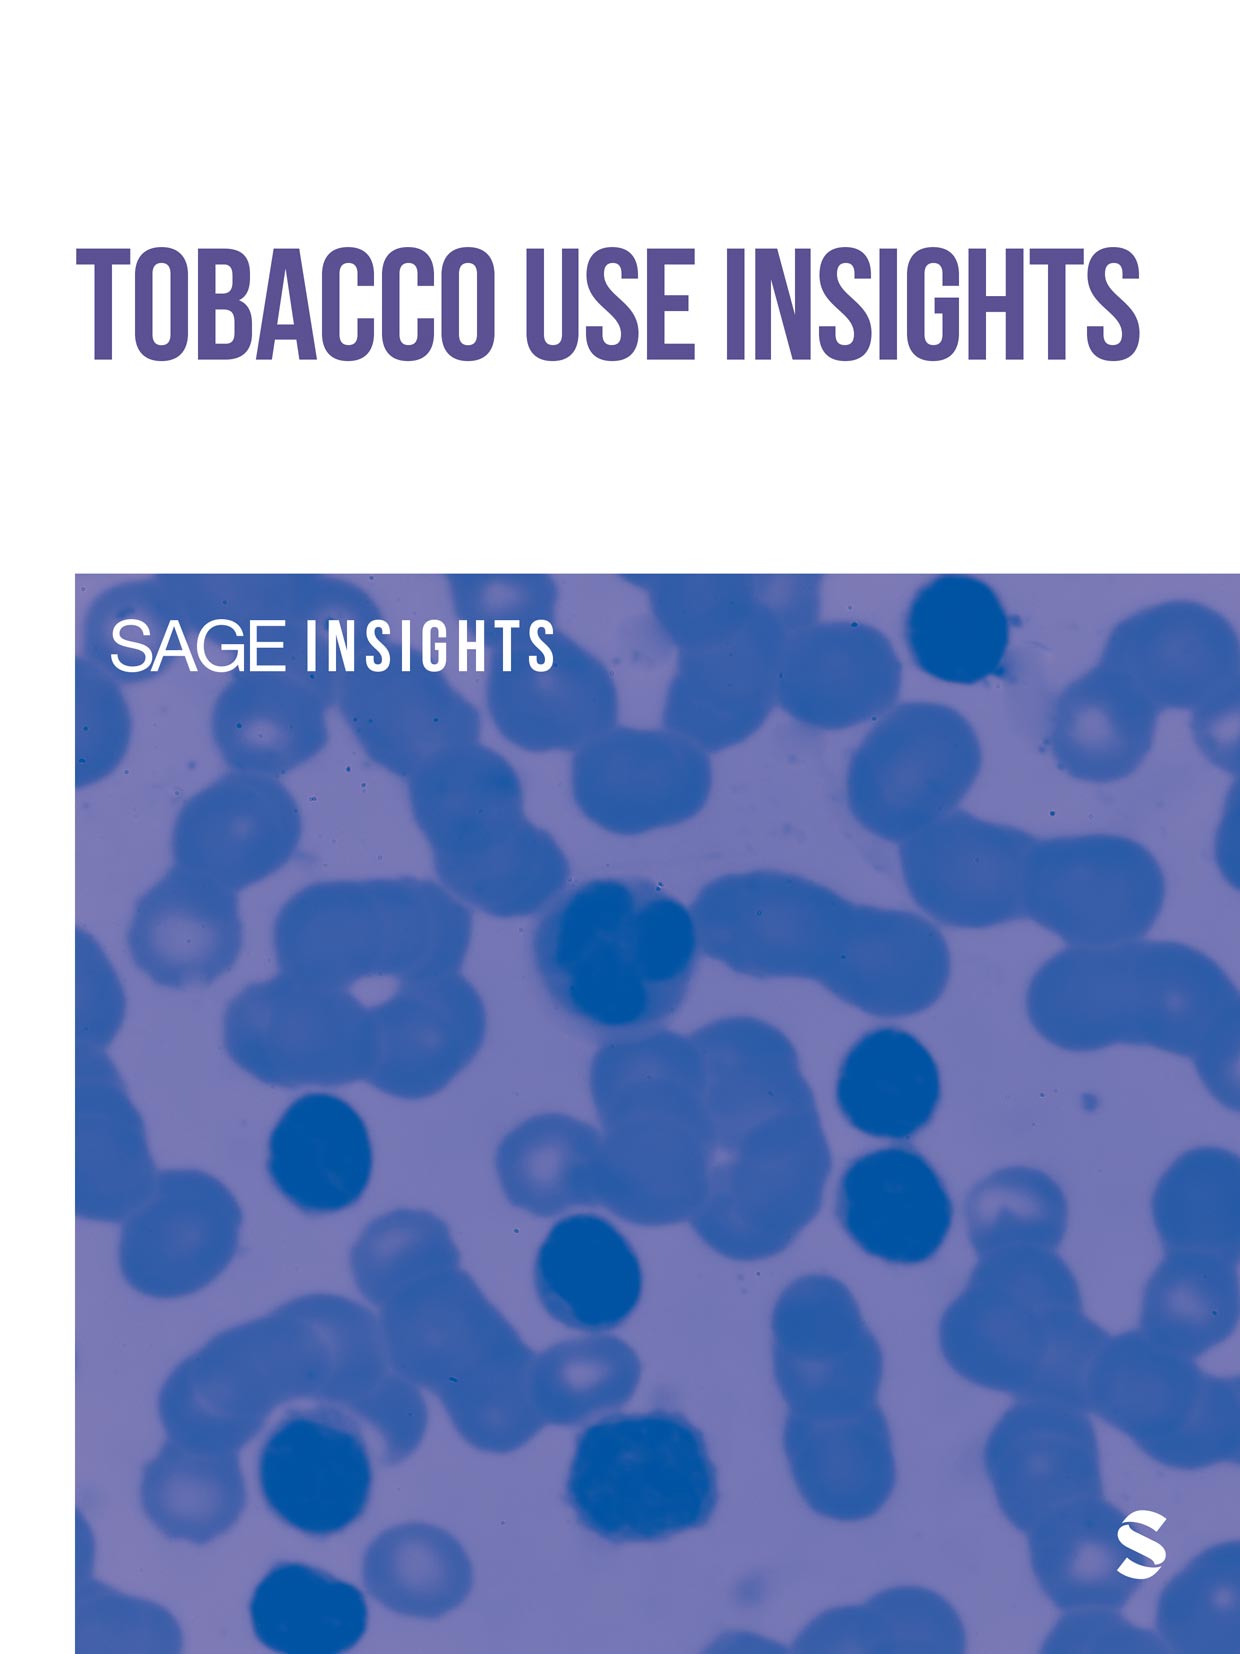

Skip to main content



Sage Health & Nursing are proud to publish a broad range of high-quality research covering public health, nursing practice, nutrition, oncology, dentistry, gerontology, palliative care, and many more health specialties. Download special issues, collections, and a selection of most read articles. Browse our journal portfolio. Explore our collections, podcasts and more.
Health & nursing books, collections and podcasts

Browse our US & UK Books List

Sage Digital Library Products

New Editor-in-Chief for Population Health Management
Meet the new Editor-in-Chief for Population Health Management and discover her vision for the journal.
Why Publish with JPSN?
Discover the top reasons to publish with Journal of Pediatric Surgical Nursing here.
JAPNA Published Special Collections
Explore an array of published special collections from the Journal of the American Psychiatric Nurses Association, covering topics from cultural competence to trauma informed care.
NASN School Nurse Podcasts
Tune into the NASN School Nurse Podcast for engaging explorations of trending topics, groundbreaking research, and the latest impactful papers.
Join the NSQ community
Nursing Science Quarterly is looking for Editorial Board members, reviewers and new submissions. Discover how you can contribute and help advance nursing knowledge.
The Journal of School Nursing Published Special Collections
Enhance your learning with the full selection of special collections from the Journal of School Nursing, on topics ranging from telehealth to asthma.
Pedagogy in Health Promotion Published Special Collections
From transformative learning to global health pedagogy, browse Pedagogy in Health Promotion's broad array of special collections.
The Health Promotion Practice Podcast
Stay up to date with podcast episodes from the Health Promotion Practice podcast, covering timely issues such as news media effects on health disparities and explorations of bystander behavioral approaches.
Health Education & Behavior Published Special Collections
Discover all published special collections from Health Education & Behavior, the industry-leading journal for discussions of theories of health behavior and health status.
Sage Health & Nursing podcasts
Tune into the latest in health and nursing with Sage podcasts, featuring cutting-edge research, trending topics, and expert insights shaping the future of health.
Latest tweets
Additional health & nursing resources
Upcoming webinar: Publishing as a Clinician
Register for How to Do Research and Get Published - Publishing as a Clinician webinar on August 12, 2026Workplace Health & Safety
WHS Society (AAOHN) EventsSOPHE
Publications and NewsletterAssociation of Diabetes Care & Education Specialists
Mentored Post-Doctoral Fellowship in Integrated Diabetes Management

Explore all Discipline Hubs, including:
- Journal portfolios in each of our subject areas.
- Links to Books and Digital Library content from across Sage.
Also from Sage
- CQ Library Elevating debateopens in new tab
- Sage Data Uncovering insightopens in new tab
- Sage Business Cases Shaping futuresopens in new tab
- Sage Campus Unleashing potentialopens in new tab
- Sage Knowledge Multimedia learning resourcesopens in new tab
- Sage Research Methods Supercharging researchopens in new tab
- Sage Video Streaming knowledgeopens in new tab
- Technology from Sage Library digital servicesopens in new tab